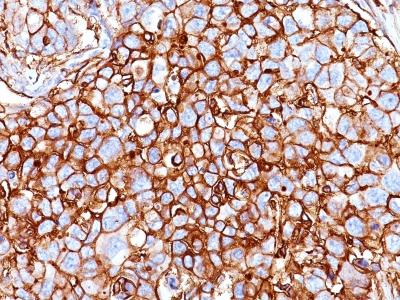

Monoclonal Antibody to CD44 / HCAM Std.(Clone : HCAM/918)
Formalin-fixed, paraffin-embedded human Breast Carcinoma stained with CD44 Monoclonal Antibody (HCAM/918)
Roll over image to zoom in
Shipping Info:
For estimated delivery dates, please contact us at [email protected]
Format : | Purified |
Amount : | 100 µg |
Isotype : | Mouse IgG2a, kappa |
Purification : | Affinity Chromatography |
Content : | 100 µg in 500 µl PBS containing 0.05% BSA and 0.05% sodium azide. Sodium azide is highly toxic. |
Storage condition : | Store the antibody at 4°C; stable for 6 months. For long-term storage; store at -20°C. Avoid repeated freeze and thaw cycles. |
Recognizes a cell surface glycoprotein of 80-95kDa (CD44) on lymphocytes, monocytes, and granulocytes (Leucocyte Typing Workshop V). Its epitope is resistant to digestion by trypsin and chymotrypsin. The CD44 family of glycoproteins exists in a number of variant isoforms, the most common being the standard 85-95kDa or hematopoietic variant (CD44s). Higher molecular weight isoforms are described in epithelial cells (CD44v), which are believed to function in intercellular adhesion and stromal binding. CD44 immunostaining is commonly used for the discrimination of urothelial transitional cell carcinoma in-situ from non-neoplastic changes in the urothelium.
Functional Studies (Order Ab without BSA & Azide); Western Blot (1-2ug/ml); Flow Cytometry (1-2ug/million cells); Immunofluorescence (1-2ug/ml); Immunohistochemistry (Formalin-fixed) (0.25-0.5ug/ml for 30 minutes at RT)(Staining of formalin-fixed tissues requires heating tissue sections in 10mM Tris with 1mM EDTA, pH 9.0, for 45 min at 95°C followed by cooling at RT for 20 minutes);
For Research Use Only. Not for use in diagnostic/therapeutics procedures.
Subcellular location: | Cell membrane, Cell projection |
Post transnational modification: | Phosphorylated; activation of PKC results in the dephosphorylation of Ser-706 (constitutive phosphorylation site), and the phosphorylation of Ser-672. |
Tissue Specificity: | Isoform 10 (epithelial isoform) is expressed by cells of epithelium and highly expressed by carcinomas. Expression is repressed in neuroblastoma cells. |
BioGrid: | 107398. 132 interactions. |
There are currently no product reviews
|